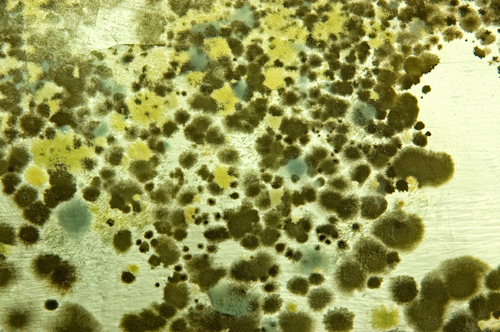

Rast plesni u domovima je vruća tema u industriji stanogradnje ovih dana nakon poplava. Naslovi u novinama upozoravaju na opasnost od izloženosti buđi u našim domovima i u kancelarijama. Buđ, član porodice gljivica, javlja se u hiljadama varijanti i postoji u svakom zatvorenom i otvorenom okruženju. Ona je prirodni i neophodni deo ekosistema u kome mi živimo. Iako mnoge vrste buđi imaju pozitivne efekte, postoji nekoliko sojeva koji mogu dovesti do zdravstvenih problema ako im se dozvoli da uspešno cvetaju u zatvorenom prostoru.
Pošto buđ može da oslobodi štetna organska jedinjenja (VOC), proizvede alergene, i uopšte utiče na kvalitet unutrašnjeg vazduha jedne zgrade, razvoj plesni ima potencijal da utiče na zdravlje stanara. Kako bi se održao zdrav ambijent u prostorijama, važno je ublažiti i sprečiti rast plesni u unutrašnjim prostorima. Mada, ukoliko potražite informacije o buđi u zgradama bićete preplavljeni sa količinama informacija - površna internet pretraga otkriva više od 40 miliona pogodaka (na engleskom jeziku prema Google pretraživaču). Imajući u vidu količinu dostupnih informacija, može biti teško steći jasnu sliku o tome šta je važno u vezi buđi i, ono što je podjednako bitno, raspoznati šta je tačno, a šta nije kada je u pitanju sprečavanje razvoja buđi i odgovarajući prateći uticaji.
Ko je u opasnosti?
Izloženost pojedinim vrstama buđi može da izazove zdravstvene probleme. Osetljivost pojedinaca i iznos izloženosti varira toliko da ne postoji „bezbedan“ prag definisan od strane vlasti. Prema Centru za kontrolu bolesti (CDC - Center for Disease Control) SAD-a, većina ljudi nema nikakvu reakciju pri „normalnoj“ izloženosti buđi, međutim neki pojedinci pokazuju veliku osetljivost na izlaganje, nalik onima koji su pogođeni polenskom groznicom. Deca, stariji građani i ljudi sa oslabljenim imunim sistemom mogu biti više osetljiviji na buđ. Iako „toksična buđ“ jeste fraza koja se najčešće pojavljuje u naslovima, Agencija za zaštitu životne sredine SAD-a (EPA) i CDC kažu da trenutno ima vrlo malo naučnih dokaza koji povezuju izloženost buđi i ekstremne bolesti, s obzirom na nizak nivo izloženosti u većini domova.
Pogrešna percepcija buđi
Postoje mnoge pogrešne predstave o buđi, ali jedna od najčešćih je da prisustvo papira, drveta i sličnih organiskih materija povećava verovatnoću rasta buđi u objektu. U stvarnosti, buđ može da raste na skoro svakoj površini gde prašina, prljavština ili organska materija može da se akumulira. To uključuje ne samo drvo i papir, već i tepih, staklo, pa čak i čelik. Nije prisustvo organskih materija ono koje izaziva problem sa buđi, već je nepravilno upravljanje vlagom i vlažnosti vazduha u zgradi ono što dovodi do raznih problema, od kojih je samo jedan razvoj buđi.
Generalno, buđ treba tri stvari za rast: spore buđi, vlagu i izvor hrane (koja može biti tako jednostavna kao što je kućna prašina). Spore buđi su svuda - one su uvek prisutne u vazduhu i u okruženju. Isto tako, zgrade su izgrađene i opremljene koristeći širok spektar organskih materijala koji mogu da služe kao izvor hrane. Prema tome, jedina efikasna strategija za kontrolu buđi jeste preko kontrole vlage.
Da biste smanjili verovatnoću razvoja kondenzacije u naseljenim objektima, zatvorena relativna vlažnost vazduha treba da se održava na nivou između 30 i 60 odsto. Uverite se da su prostorije poput kupatila, kuhinja, ostava, sušara i drugih izvora vlage dobro ventilirana (mehaničkim ili prirodnim putem), i takođe se nemojte libiti korišćenja klimatizacije i odvlaživača vazduha.
Iako je izolovanje spoljašnjih zidova, krova, odvoda i cevi od suštinskog značaja za energetsku efikasnost, ove površine mogu razviti buđ ukoliko se ne preduzmu mere predostrožnosti tokom instalacije. Da bi se smanjio potencijal kondenzacije na hladnim površinama, važno je ugraditi dobro zapečaćenu vazdušnu barijeru i retarder vlage na toploj, unutrašnjoj strani zida ili krova kako bi se blokirao vazdušni upad vlage.
U slučaju upada vode, čisti i suvi građevinski materijali i nameštaj postaju vlažni ili mokri, a u roku od 48 časova se razvija buđ. Očistite buđ sa tvrdih površina sa vodom i deterdžentom, a zatim u potpunosti osušite površine. Međutim, budite svesni da će upijajući materijali kao što su tepisi i postava koje postanu buđavi možda morati da se zamene.

Odakle dolazi vlaga?
Curenja i poplave: Većina velikih problema sa buđi se prepisuje velikim količinama vode. Curenje se može desiti u vodovodnim i kanalizacionim instalacijama, krovu ili zidovima. Ovo se često dešava zbog neodržavanja tih komponenti, šteti usled neke prirodne nepogode ili nepravilne postavke materijala. Neprimećeno malo curenje može da dovede do velikih problema. Prskalice za baštu bi trebalo postaviti tako da prskaju dalje od spoljašnjih zidova doma. Kuće treba isušiti u roku od 24 do 48 sati od curenja ili poplave, naravno ukoliko je to moguće.
Kondenzacija: Svi su upoznati sa kondenzacijom vodene pare na hladnom piću tokom toplog letnjeg dana. Ista stvar može da se desi na prozorima u zimskim danima, ili na hladnoj cevi za vodu ili klimatizacionom kanalu u toploj, vlažnoj klimi. Ukoliko se ostavi nekontrolisana, ova kondenzacija može da akumulira i stvori idealne uslove za rast buđi.
Prodor vazduha: Kako vetrovi duvaju prema objektu, vazduh može da se ušunja kroz rupe u oblogi, ispod pragova, oko vrata i prozora, kao i preko električnih utičnica. Ukoliko postoji velika razlika između unutrašnjih i spoljašnjih temperatura, vodena para može da kondenzuje u šupljinama, ili iza zidnih obloga, kako prolazi kroz izolaciju i hladi se do tačke rošenja. Jednom kada se tečna voda sakupi u šupljini, buđ može da počne da raste.
Bez obzira na izvor, višak vode bi trebao da se očisti što je pre moguće, a pogođene materijale bi trebalo osušiti. Ukoliko sumnjate da imate ozbiljan problem sa rastom buđi u vašem domu, potražite savet od profesionalaca.
Proizvodi otporni na buđ
Postoji veliko interesovanje po pitanju proizvoda otpornih na buđ u poslednjih nekoliko godina. Iako postoji mnogo takvih proizvoda koji su dostupni, njih ne treba smatrati čudotvornim lekom koji će sprečiti buđ u svim okolnostima. Proizvodi otporni na buđ, što uključuje određene gips ploče i zidne obloge otporne na vlagu i buđ, obezbeđuju dodatnu robusnost koja pomaže kada neželjena vlaga uđe u objekat. Ovaj dodatni nivo zaštite u slučaju upada vode, manje poplave ili izlivanja na kraju neće uspeti u njihovoj nameni ukoliko su proizvodi stalno izloženi vlazi. Dakle, smatrajte proizvode otporne na buđ kao dodatnu polisu osiguranja, a ne kao na primarnu liniju odbrane. Oni nisu zamena za pogodan sistem upravljanja vlagom, odgovarajuće građevinske prakse i dobro održavanje.
Samo tehnologije „čiste sobe“, koje se obično koriste u visokotehnološkoj proizvodnji i u naučno-istraživačkim ustanovama za visoko specijalizovane primene kao što je proizvodnja mikročipova, mogu u potpunosti da eliminišu spore buđi iz prostorije. Ove tehnologije čvrsto kontrolišu nivo zagađujućih materija – kao što su prašina, mikrobi u vazduhu, aerosolne čestice i hemijska isparenja - ali one su previše skupe i previše nepraktične za većinu objekata u kojima ljudi žive i rade. U većini slučajeva, primarna odbrana protiv rasta buđi jeste kontrola količine vode koja ulazi u zgradu.

Drugi potencijalni problemi
Nažalost, upad vlage predstavlja više od puke pretnje izbijanja plesni u zgradi. Vlažna sredina takođe podstiče rast grinja i bakterija, što zauzvart može uticati na kvalitet unutrašnjeg vazduha, a može da privuče i insekte, glodare i druge štetočine. Vlaga će na kraju oštetiti materijale, i učiniće zgradu manje vrednom i smanjiće njen životni vek. Sve ovo znači da je važno tretirati višak vode sa istim osećajem hitnosti kao što biste tretirali jedan tinjajući požar. Odmah identifikujte odakle voda dolazi, zaustavite je i osušite ili zamenite materijale koji su vlažni.
Dobro se upoznajte sa nekim od znakova raspoznavanja buđi, uključujući vlagu, neprijatne mirise, promenu boja, ljuštenje boja, kondenzaciju i zbijenu izolaciju. Sezonski pregledi celokupnog objekata, a posebno zavučenih prostora kao što su potkrovlja će vam pokazati da li u njima ima naznaka razvoja buđi – svaka vidljivo komrpomitovana izolacija, promena boje na vrhu ili dnu zidova, kao i neprijatni miris. Sertifikovani stručnjaci imaju različite tehnike da provere ovo, počevši od sondiranja unutar šupljina u domu do termografskih analiza korišćenjem infracrvene kamere.
Dobra smernica je sprovoditi kvartalnu inspekciju ovih prostora unutar objekta kako bi se tražilo prisutvo vode ili vlage. Ukoliko otkrijete bilo koje znake vlage, uverite se odakle voda dolazi i gde odlazi. Preduzmite korake da zaustavite prodor vode, i kada osušite taj prostor, procenite da li neki od građevinskih materijala (ili nameštaja) mora da se zameni.
Suva zgrada sprečava ne samo pojavu buđi, već i stvara više prijatnu, zdravu životnu sredinu. Suva zgrada je više izdržljivija i ima manje problema prilikom održavanja. Kontrola vlage je zaista dobitna situacija za građevinske profesionalce, podjednako kao i za vlasnike objekata i stanare.




























;